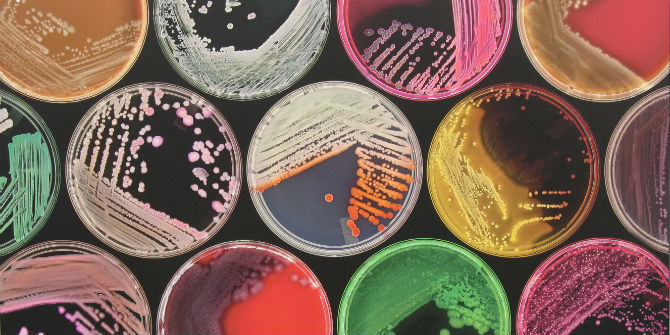
میکروب شناسی : حقایقی جالب درمورد میکروب ها

میکروب شناسی : حقایقی جالب درمورد میکروب ها
گروه زیست شناسیحقایقی جالب درمورد میکروب ها ۱-سلول های باکتریایی بدن شما بسیار بیشتر از سلول های انسانی است. ۲-احتمال اینکه صاعقه به شما بخورد بیشتر است تا اینکه توسط کوسه خورده شوید.احتمال ابتلای شما به باکتری های گوشت خوار بیشتر از برخورد صاعقه است. ۳-هدفون های پلاستیکی نرمی که در هواپیماها استفاده می شود، محیط گرم و مرطوبی را در کانال گوش ایجاد می کند که برای رشد باکتری ها ایده آل است. ۴-محققان یک باکتری 250 میلیون ساله به نام Bacillus permians را که در کریستال های نمک کشف شده بود، احیا کردند. ۵-تصور می شود که الماس ها از کربن و باکتری های مرده ساخته شده اند. ۶-محققان کشف کرده اند که باکتری ها در ابرها زندگی می کنند و رشد می کنند. ۷-میکروبهای مریخ ممکن است روی صخرههای مریخی که در اثر برخورد شهابها به فضا پراکنده شدهاند به زمین سفر کرده باشند. 4 سال پیش
| رشتهها و جمعیت گروه زیست شناسی |
|---|
